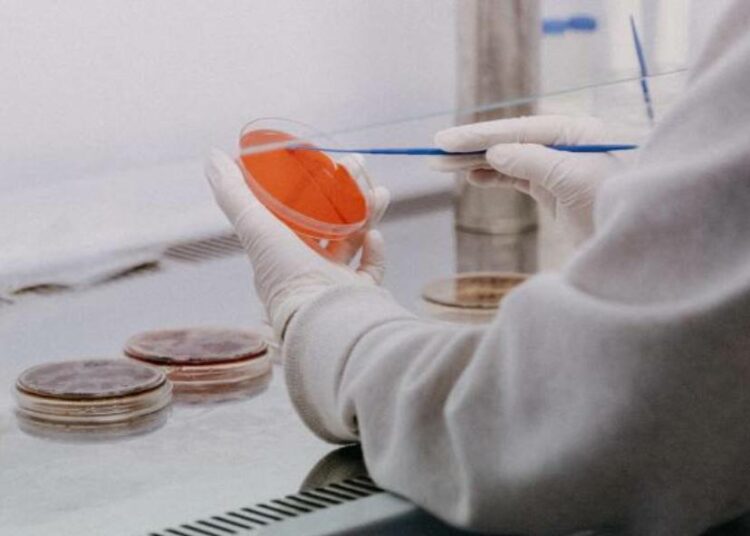
Detectaron un caso de viruela del mono en Maryland en una persona que acababa de llegar desde África

El Departamento de Salud del estado de Maryland (MDH), en colaboración con los Centros para el Control y la Prevención de Enfermedades (CDC) de Estados Unidos, confirmaron este martes un caso de infección por el virus de la viruela del mono en un residente local que regresó recientemente de Nigeria.
La persona infectada presentaba síntomas leves y se está recuperando en aislamiento. Las autoridades sanitarias dijeron que no se encuentra hospitalizado. Asimismo, por el momento no hicieron recomendaciones con precauciones especiales para el público en general.
“Las autoridades de salud pública han identificado y continúan haciendo un seguimiento de las personas que pueden haber estado en contacto con el individuo diagnosticado”, dijo la Dra. Jinlene Chan, Subsecretaria de Salud Pública del MDH. “Nuestra respuesta en estrecha coordinación con los funcionarios de los CDC demuestra la importancia de mantener una fuerte infraestructura de salud pública”, agregó.
La viruela del mono pertenece a la misma familia de virus que la viruela, pero suele causar una infección más leve. Puede contagiarse entre personas a través del contacto directo con lesiones cutáneas o fluidos corporales, o con materiales contaminados como ropa o sábanas. También puede propagarse a través de grandes gotitas respiratorias que, por lo general, no pueden viajar más allá de unos pocos metros, y se requiere un contacto prolongado cara a cara.
La enfermedad suele comenzar con síntomas parecidos a los de la gripe e inflamación de los ganglios linfáticos, y evoluciona hacia una erupción generalizada en la cara y el cuerpo. La mayoría de las infecciones duran entre 2 y 4 semanas. Los individuos identificados como potencialmente expuestos a este caso serán vigilados para detectar síntomas de viruela del mono durante los 21 días posteriores a la exposición, informó el Departamento de Salud de Maryland.
Las infecciones de viruela del mono en humanos se producen principalmente en los países de África central y occidental y sólo se han documentado en raras ocasiones fuera de África. Aunque todas las cepas pueden causar la infección, las que circulan en África occidental, donde se encuentra Nigeria, suelen causar una enfermedad menos grave, según las autoridades de Maryland.